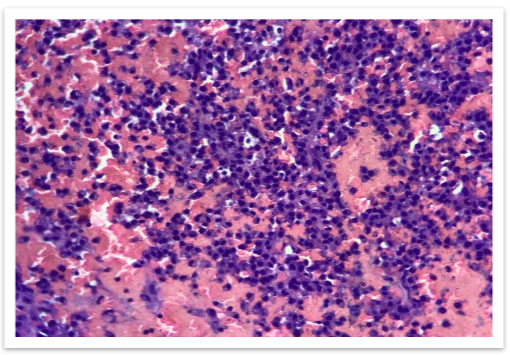
FIG 4: High power view(100x) - Clusters of plasma cells with eccentric nucleus and basophilic cytoplasm.

Uncommon Non-Secretory Myeloma: A Case Study
The Hidden Enemy: A Case Report on an Uncommon Variant of Non-Secretory Myeloma
Dr. Shobana B1,4 Dr. Annie Nitisha C2, Dr. S. Mary Lilly3,4
- Assistant Professor in Pathology; Department of Pathology, Sree Balaji medical college and hospital, Chrompet, Chennai-44
- Professor & HOD in Pathology;
- Department of Pathology, Sree Balaji medical college and hospital, Chrompet, Chennai-44
OPEN ACCESS
PUBLISHED:31 May 2025
CITATION:B, Dr. Shobana; C, Dr. Annie Nitisha; MARY LILLY, Dr. S.. The Hidden Enemy: A Case Report on an Uncommon Variant of Non-Secretory Myeloma. Medical Research Archives, [S.l.], v. 13, n. 5, may 2025. Available at: <https://esmed.org/MRA/mra/article/view/6610>.
DOI: https://doi.org/10.18103/mra.v13i5.6610
ISSN 2375-1924
Abstract
Multiple myeloma (MM) is a malignant proliferation of plasma cells producing a monoclonal paraprotein. Multiple myeloma can present in a wide range of ways for example hypercalcaemia, hyper viscosity, renal failure and bone pain. This paper presents a case of non-secretory multiple myeloma presented with only symmetrical recurrent joint swelling. This patient did not have any detectable monoclonal protein in serum or urine. The absence of a monoclonal protein in serum and/or urine does not rule out the diagnosis of multiple myeloma.
Keywords
- Non-secretory multiple myeloma
- Monoclonal protein
- Joint swelling
- Diagnosis
Introduction
Non-secretory myeloma (NSM) is a malignant proliferation of plasma cells that produces no detectable monoclonal paraprotein causing hypercalcemia, as well as CRAB characteristics (bone lesions, anemia, hypercalcemia, and renal insufficiency).1 The disease has a wide range of symptoms from asymptomatic to quite severe. It accounts for about 1% of malignant tumours, 10-15% of haematological neoplasms, and 20% of deaths from haematological malignancies.2,3 Physical findings are often absent or nonspecific, with pallor being the most common.
In about 97% of cases, MM can be diagnosed in the hospital with the help of clinical history and examination, but in some cases, it can be difficult to diagnose. In this case report, we present a patient who had difficulty in walking due to joint swelling. On examination, no swelling was noted in the joints, and a thorough investigation was done to rule out other causes of joint pain.
Case Report
A 70-year-old female patient was admitted to the hospital with the chief complaint of pain and difficulty in walking at myeloma levels but was found to have joint swelling. A thorough investigation was done to rule out other causes of joint pain. The patient had no history of trauma or any other significant medical history. On examination, there was no swelling noted in the joints, and the patient was found to have a normal range of motion.

Serum protein electrophoresis was performed, and it was reported as normal (Figure 1). MRI was done to rule out any underlying pathology.

The MRI findings showed multiple focal altered signal intensity lesions (Figure 2). A bone biopsy was performed, and histopathological examination revealed the presence of plasma cells.

Immunohistochemistry showed plasmacytoid cells are positive for CD 138 (Figure 6). The patient was diagnosed with non-secretory multiple myeloma.

Discussion
Plasma cell myeloma (PCM) is a rare tumor-based, multi-focal neoplastic proliferation of plasma cells, usually accompanied by the production of a monoclonal immunoglobulin detectable in the serum, urine or both.4 Multiple myeloma (MM) is characterized by the production of monoclonal proteins, which can be detected in serum or urine.5 According to previous research, NSMM may not have a typical clinical or radiologic presentation compared to the presence of the protein in serum and/or urine.6 The incidence is even higher in females than in males.7 Osteolytic lesions in the skull, ribs, shoulders, and vertebrae are common findings in patients with MM, but in NSMM, these findings may be absent.8
Conclusion
The absence of a monoclonal protein in serum and/or urine does not rule out the diagnosis of Multiple Myeloma. Indeed, the diagnosis of non-secretory myeloma should be made in patients with clinico-pathological and radiological characteristics of Multiple Myeloma with a ratio of normal Kappa/Lambda free light chains. This case demonstrates that non-secretory myeloma has a high degree of suspicion.
References
- Kumar V, Abbas AK, Fausto N. Robbins and Cotran pathologic basis of disease. W B Saunders Co. (2017) ISBN: 9781626210871.
- Jodin SR. Goldblum, Jesse K. McKenney, Rosa and Ackerman’s surgical pathology, eleventh edition.
- WHO Classification of tumors of haematopoietic and lymphoid tissues (fifth edition).
- Geng Guichang, Li Du Xi, Li Zhang Wenjie, Zhang Guozhong, Gie Li, Liang Li, et al. Consensus recommendations for standard investigative work-up: report of the International Myeloma Workshop Consensus Panel 3. Blood. 2011; 117:5830-5832.
- Dupuis MM, Tuchman SA. Non-secretory multiple myeloma: a rare variant of multiple myeloma that has a similar clinical and radiologic presentation. Hematol Oncol Clin North Am. 2016; 9:7830-7810.